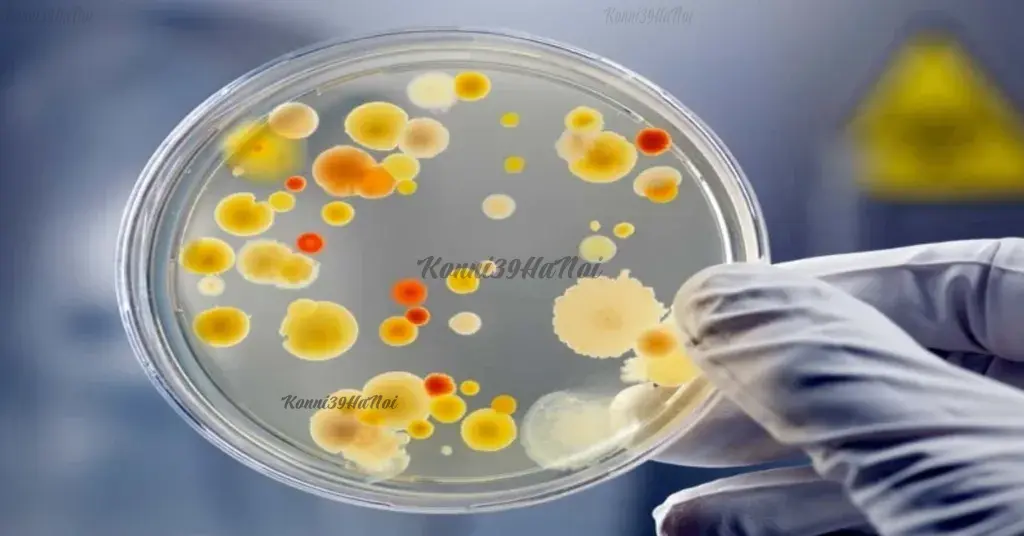
vi_khuan_trong_my_pham_4e6d6c02ca184bcab11fdaf0d4188b9e_1024x1024 Mỹ phẩm hết hạn chứa nhiều vi khuẩn gây hại

Mỹ phẩm hết hạn nhưng chưa mở nắp thì còn dùng được không? Cách nhận biết
Mỹ phẩm hết hạn nhưng chưa mở nắp thì còn dùng được không? Cách nhận biết

Câu hỏi về việc mỹ phẩm hết hạn nhưng chưa mở nắp có còn sử dụng được không luôn khiến nhiều người băn khoăn. Thực tế, những sản phẩm chưa tiếp xúc với không khí có thể vẫn giữ được một phần chất lượng ban đầu, tuy nhiên không có nghĩa là chúng hoàn toàn an toàn. Cùng KONNI39HANOI tìm hiểu cách nhận biết mỹ phẩm đã hết hạn và những dấu hiệu cảnh báo sẽ giúp bạn đưa ra quyết định đúng đắn để bảo vệ làn da và sức khỏe của mình nhé!
Hạn sử dụng của mỹ phẩm là gì? Nếu chưa mở nắp thì sản phẩm có bị ảnh hưởng không?
Hạn sử dụng của mỹ phẩm là mốc thời gian được in trên bao bì, đây là cam kết của nhà sản xuất về chất lượng, độ an toàn và tính ổn định của mỹ phẩm vẫn được giữ hiệu quả, không gây hại cho làn da trong thời hạn sử dụng nếu chưa mở nắp và bảo quản đúng cách.
Các ký hiệu được in trên bao bì dùng để xem thời hạn sử dụng giúp người dùng tránh những rủi ro về việc mỹ phẩm bị hư, bao gồm:
-
EXP (Exprity date): ngày hết hạn được nhà sản xuất xác định (Không sử dụng mỹ phẩm sau khoảng thời gian này).

Ký hiệu ngày hết hạn sản phẩm
-
PAO (Period After Opening): Biểu tượng chiếc hộp mở nắp kèm số tháng sử dụng sau khi mở như 12M.

Ký hiệu hạn sử dụng mỹ phẩm sau khi mở nắp sản phẩm
Một số tác hại khi sử dụng mỹ phẩm hết hạn?
Mỹ phẩm dù chưa mở nắp nhưng thời hạn sử dụng sản phẩm đã hết thì cũng tiềm ẩn nhiều rủi ro trong sản phẩm. Dưới đây là một số tác hại khi sử dụng mỹ phẩm đã hết hạn:
Chứa nhiều vi khuẩn có hại
Theo nhiều nghiên cứu từ chuyên gia, các vi khuẩn có hại như Eubacterium, Aeromonas, Propionibacterium, Enterobacter,… sẽ xuất hiện nhiều trong các mỹ phẩm đã hết hạn. Những vi khuẩn này là nguyên nhân gây ra các bệnh viêm âm đạo, viêm dạ dày, nhiễm tùng hay nặng hơn là viêm màng não và nhiễm trùng huyết dẫn đến trường hợp tử vong.
Mỹ phẩm hết hạn chứa nhiều vi khuẩn gây hại
Gây kích ứng da
Khi mỹ phẩm hết hạn cũng là lúc các thành phần, kết cấu sản phẩm đã thay đổi, không những sản phẩm bị mất tác dụng mà thậm chí còn dẫn tới tình trạng người dùng bị nổi mẩn đỏ, tùy vào từng người mà sẽ có biểu hiện khác nhau. Tệ hơn là khi các mỹ phẩm hết hạn đi sâu vào các tế bào da, làn da sẽ dần tích tụ các độc tố và tăng khả năng bị ung thư da.
Khiến làn da trở nên yếu hơn
Sau giai đoạn kích ứng nổi mẩn đỏ, viêm da do sử dụng mỹ phẩm hết hạn sẽ khiến bề mặt da ngày càng bị bào mỏng, dần trở nên yếu, nhạy cảm hơn và các dễ bị tổn thương hơn khi tiếp xúc với môi trường.

Sử dụng mỹ phẩm hết hạn khiến làn da trở nên yếu hơn
Giảm tác dụng sản phẩm
Khi hết hạn, các loại mỹ phẩm sẽ không còn giữ được những công dụng ban đầu do kết cấu thành phần bị thay đổi, biến chất, thậm chí là mất công dụng. Vì vậy, sử dụng các mỹ phẩm hết hạn sẽ không mang lại bất cứ hiệu quả nào cho làn da.
Các yếu tố ảnh hưởng đến hạn sử dụng của mỹ phẩm?
Có nhiều yếu tố bên ngoài cũng là nguyên nhân gây ảnh hưởng đến hạn sử dụng của mỹ phẩm. Dưới đây là một số yếu tố bạn cần quan tâm để có thể kéo dài tuổi thọ của mỹ phẩm:
Môi trường bảo quản sản phẩm
Nên bảo quản sản phẩm ở nơi thoáng mát, khô ráo. Tránh những nơi ẩm ướt (như phòng tắm) vì sẽ làm cho vi khuẩn, nấm mốc phát triển mạnh hơn. Đồng thời, tránh để sản phẩm tiếp xúc với ánh nắng trực tiếp bởi nhiệt độ cao sẽ làm cho thành phần trong mỹ phẩm phân hủy nhanh hơn, phá hủy kết cấu sản phẩm, làm cho quá trình sử dụng không đạt hiệu quả.
Thành phần có trong sản phẩm
-
Mỹ phẩm có nguồn gốc từ thiên nhiên: Do không chứa chất bảo quản, sản phẩm sẽ nhạy cảm hơn với môi trường. Khi ảnh hưởng dưới tác động của nhiệt, độ ẩm và ánh sáng thì các thành phần trong sản phẩm dễ bị oxi hóa, dẫn đến mất hiệu quả hoặc biến đổi cấu trúc.
-
Công thức hóa học có trong sản phẩm với liều lượng ổn định: Với một số chất bảo quản và hợp chất hóa học ổn định trong mỹ phẩm giúp duy trì chất lượng sản phẩm lâu hơn. Tuy nhiên, việc sử dụng những sản phẩm này cũng đi kèm với những nguy cơ tiềm ẩn cao hơn đối với sức khỏe người dùng.
Cách để nhận biết các loại mỹ phẩm đã hết hạn
Ngoài cách xem hạn sử dụng của mỹ phẩm qua bao bì, dưới đây là một số cách để đánh giá tình trạng của mỹ phẩm:
Màu sắc của mỹ phẩm
Kiểm tra màu sắc sản phẩm so với ban đầu, nếu có thay đổi về màu sắc thì chắc chắn sản phẩm cũng đã bị biến đổi thành phần trong sản phẩm (thường là tình trạng oxhi hóa). Sản phẩm lúc này không còn đảm bảo độ an toàn để sử dụng nữa.
Kết cấu của mỹ phẩm
Có thể dùng tay hoặc dụng cụ sạch chấm vào sản phẩm để kiểm tra kết cấu. Nếu sản phẩm có các tình trạng bị tách lớp, vón cục hay xuất hiện lớp màng thì hãy nhanh chóng vứt đi, tuyệt đối không tiếp tục sử dụng nữa.
Bị tách lớp
Đây là tình trạng sản phẩm bắt đầu phân hủy, thường có lớp dầu hoặc nước nổi trên bề mặt của sản phẩm. Ngoài lý do sản phẩm đã hết hạn sử dụng thì còn là do môi trường bảo quản sản phẩm không phù hợp.
Bị vón cục
Các sản phẩm ở dạng kem, sữa hoặc dầu bị vón cục là dấu hiệu cho thấy công thức sản phẩm đã bị biến đổi hoặc phá vỡ.
Mùi của mỹ phẩm
Trường hợp mỹ phẩm có mùi hương lạ, khác hoàn toàn so với mùi hương ban đầu, đây là dấu hiệu rõ ràng khi sản phẩm bị nhiễm khuẩn, mốc.
Khi nào thì có thể sử dụng mỹ phẩm hết hạn?

Trường hợp có thể sử dụng mỹ phẩm đã hết hạn
Đúng là những sản phẩm hết hạn thì không nên sử dụng nữa. Tuy nhiên, trong một số trường hợp cấp bách, bạn vẫn có thể tạm sử dụng các mỹ phẩm hết hạn:
-
Những sản phẩm dạng khô, không chứa nước sẽ ít bị vi khuẩn thâm nhập, nếu bảo quản tốt thì vẫn có thể tiếp tục sử dụng.
-
Các loại mỹ phẩm trang điểm như bút kẻ mắt, má hồng,… khi hết hạn thì bạn vẫn có thể tiếp tục sử dụng khi cấp bách.
Trên đây là câu trả lời Liệu rằng mỹ phẩm hết hạn nhưng chưa mở nắp thì có thể sử dụng được không? Để mua các sản phẩm nội địa Nhật uy tín, bạn có thể ghé thăm Konni39hanoi . Các sản phẩm của Konni39hanoi thường có tem phụ tiếng Việt ghi rõ công dụng, thành phần và hạn sử dụng. Hãy liên hệ tớifanpage và website hoặc ghé cửa hàng/siêu thị Konni39hanoi gần nhấtđể mua sắm nhanh nhất.
Hotline: 0982.575.126

Chăm sóc cơ thể
Chăm sóc da mặt
Chăm sóc răng miệng
Chăm sóc tóc
Dụng cụ làm đẹp
Chống nắng
Dưỡng môi & mi
Dưỡng trắng
Giấy thấm dầu
Mặt nạ
Nước hoa hồng
Serum & kem dưỡng
Sữa rửa mặt
Tẩy da chết
Tẩy trang
Bàn chải
Chỉ nha khoa
Kem đánh răng
Nước súc miệng
Xịt họng
Cạo râu
Dầu gội – Dầu xả
Nhuộm tóc
Tẩy lông
Trang điểm mắt
Trang điểm mặt
Collagen
Enzyme
Hỗ trợ mọc tóc
Tăng & giảm cân
Seedcoms
Trẻ hóa làn da
Trị nám
Tăng cường sức khỏe
Bổ dạ dày
Bổ não
Bổ phổi & gan
Bổ xương khớp
Tăng cường sinh lý
Hỗ trợ điều trị
Đồ dùng nấu bếp
Đồ điện đun nấu
Nồi chảo Oceno
Đồ dùng cá nhân
Băng vệ sinh
Bao cao su
Đồ dùng khác
Nhà bếp
Dao & Kéo
Hóa phẩm nhà bếp
Hộp đựng thức ăn
Nước rửa chén bát
Phòng ăn
Bình nước, bình giữ nhiệt
Dung dịch tạo hương
Đồ dùng phòng tắm
Giặt xả
Diệt & chống côn trùng
Ngoài trời & sân vườn
Đồ sửa chữa
Chăm sóc cơ thể bé
Gội đầu – Sữa tắm cho bé
Phấn, kem dưỡng da cho bé
Khăn giấy ướt
Chăm sóc sức khỏe cho bé
Hạ sốt
Tai mũi họng
Tăng chiều cao
Vitamin & khoáng chất
Chăm sóc răng miệng cho bé
Nước súc miệng
Đồ dùng cho bé
Bình sữa – Bình tập uống
Dụng cụ tập ăn
Đồ chơi
Gặm nướu, ti giả
Tã – Bỉm
Đồ dùng cho mẹ
Thực phẩm bổ sung cho mẹ
Thực phẩm cho bé
Bánh ăn dặm
Cháo & bột ăn dặm
Bánh kẹo cho bé
Gia vị nấu nướng cho bé
Hạt nêm
Mì chính, đường, muối
Nước dùng
Nước tương
Kẹo cao su
Thạch
Bánh
Kẹo
Socola
Đồ uống
Nước giải khát
Trà – Coffee
Sữa dinh dưỡng
Thực phẩm ăn liền
Đồ hộp
Ngũ cốc
Đồ lót
Khẩu trang & Túi